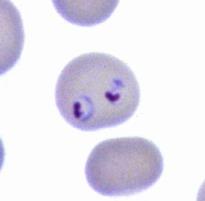

平成21年度科学研究費補助金に採択された無細胞生命科学工学研究センター 坪井敬文教授からメッセージをいただきました。
科学研究費補助金 基盤研究(A) 平成21年度採択課題
マラリア原虫メロゾイト先端部小器官分子に対するヒト赤血球レセプターの網羅的同定
無細胞生命科学工学研究センター 教授 坪井敬文
マラリアは熱帯・亜熱帯地域を中心に広く分布しており、年間約3億人が罹患、死亡者は100万人を大きく上回っています。現在治療薬に耐性の熱帯熱マラリアが猛威をふるっており、ワクチンの開発が求められていますが、実用化された物はありません。このように、マラリアに対する新しい薬やワクチンの開発が切望されていますが、そのカギとなる病気が起こる仕組みは、実はほとんど判っていません。
マラリアという病気は、メロゾイトと呼ばれる原虫がヒト血中の赤血球に侵入し、その中で増殖・破壊することで起こります。このメロゾイト先端部に存在する特殊な細胞内小器官は、赤血球への侵入に必須の分子を含むと考えられています。さらに、侵入には先端部小器官の原虫側リガンド分子が、赤血球表面のレセプターと結合することが必須と考えられていますが、それらの同定は一部を除いて進んでいません。その理由の一つは、マラリア原虫遺伝子からタンパク質を合成するための技術が確立していないことでした。これまでに私たちは、愛媛大学で開発されたコムギ胚芽無細胞タンパク質合成系を用いることにより、多種のメロゾイト先端部小器官タンパク質の合成に成功しました。そこで本研究では、コムギ無細胞系を応用したハイスループットな分子間相互作用のスクリーニング系を用いることによって、メロゾイトのリガンド分子と相互作用を有する赤血球レセプター分子をゲノムワイド網羅的に同定し、赤血球侵入における宿主・マラリア原虫分子間ネットワークの解明を目指します。本研究は、マラリア原虫メロゾイト先端部小器官分子の赤血球侵入における役割を解明するのみならず、メロゾイト先端部小器官分子を標的とするワクチン開発にとって有用な情報を得ることが出来ると考えています。したがって、この研究は、機能の理解に基づいた新しいマラリアワクチンのデザインにもつながる可能性があると夢を膨らませています。
マラリア撲滅に向けての道のりは今後も険しいことに変わりはありませんが、流行地の人々がマラリアに怯えて暮らす日々が解消されることを目指して出来る限りの努力をしたいと考え、研究を続けています。
最後に、私が科研申請書を作成する際には、応募しようとする分野の過去の採択課題、審査員等には目を通し、どのような審査員の方に読んでいただくかを常に意識しています。また、関連分野の学会発表にも積極的に取り組み、審査員になるであろう方々に自分たちの研究の意味がわかっていただけるような発表になるよう心がけています。
- 坪井教授
- マラリア原虫が感染した赤血球